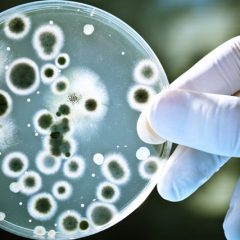
BeC Natura – când tradiția și cercetările moderne din chimie și biochimie își dau mâna

Gabor Group – specialiștii italieni în produse pentru epilat cu vânzări record
Povestea companiei Gabor începe în anii ‘60, când Bruno Ferrando și soția sa Laura au început să producă și să distribuie produse cosmetice pentru drenaj limfatic și de sculptare a corpului. În 1960 Gabor este deja o prezență de succes în domeniul parfumeriei, dar abia în 1978 compania capătă o notorietate remarcabilă prin campaniile de publicitate pentru crema de plajă Taboga. Fiul celor doi fondatori, Aldo Ferrando se alătură...
G.V.F. – specialiști în cosmetice profesionale de peste 30 de ani
Grupul de firme G.V.F. este activ în sectorul produselor cosmetice profesionale de peste 30 de ani. Constituită în anul 1987 de către Lucio Fusaro, compania își desfășoară activitatea în sectorul hairdressing profesional. Produsele de colorare a părului cu marca ITELY HAIRFASHION sunt realizate în Milano. Tipologia produselor care sunt realizate în totalitate în Italia merg de la vopsele de par, la tratamente pentru piele, la...
Equilibra – suplimente alimentare și cosmetice naturale „Made in Italy”
Equilibra este o companie italiană care produce suplimente alimentare și cosmetice naturale, fondată în 1987 la Torino de către inginerul Franco Bianco. Având mai mult de 9000 de puncte de vânzare în peste 20 de țări din întreaga lume, Equilibra a ajuns pe piața românească în anul 2015. Diviza companiei este „Sănătate la îndemâna tuturor”, în 2008 aceasta intrând și în domeniul farmaceutic prin achiziția mărcii Syrio. Doi ani...
Histomer – primul brand care introduce celulele stem de origine vegetală în produsele de frumusețe
Histomer este o marcă italiană de produse cosmetice profesionale, deținută de compania Cosmeteria Verde. Histomer este primul brand cosmetic din lume care a inițiat studierea posibilității de aplicare a celulelor stem de proveniență vegetală în câmpul dermatologiei estetice. În ultimele decenii din secolului trecut, în colaborare cu laboratoarele Histo-lab din Geneva, acesta a reușit să aducă pe piață primele produse cosmetice bazate...
BeC Natura – când tradiția și cercetările moderne din chimie și biochimie își dau mâna
BeC Natura este o companie de referință în materie se produse cosmetice și suplimente alimentare naturale pe piața din Italia. Compania a fondată la începutul anilor ’80 în Forlì, oraș italian din regiunea Emilia-Romagna, și îi are în continuare în conducerea companiei pe cei doi fondatori ai săi, fiind gestionată la nivel familial. Cercetătorii BeC s-au aplecat în cercetările lor asupra modului în care uleiurile esențiale și...
Laboratoarele Arval se preocupă de frumusețe cu pasiune italiană și tehnologie elvețiană
Înființate în 1952 în inima Valaisului, unul dintre cantoanele Elveției înconjurat de ghețari din care încă se mai obține apă pură folosită în formule produselor, Laboratoarele Biologice Arval îmbină pasiunea italiană pentru frumusețe cu tehnologia elvețiană. Avându-i ca fondatori pe Nadja Avalle și Jean-Pierre Rapaz, Arval oferă de peste 60 de ani „rețetele” frumuseții pe întreg mapamondul, fiind cunoscută mai ales pentru...